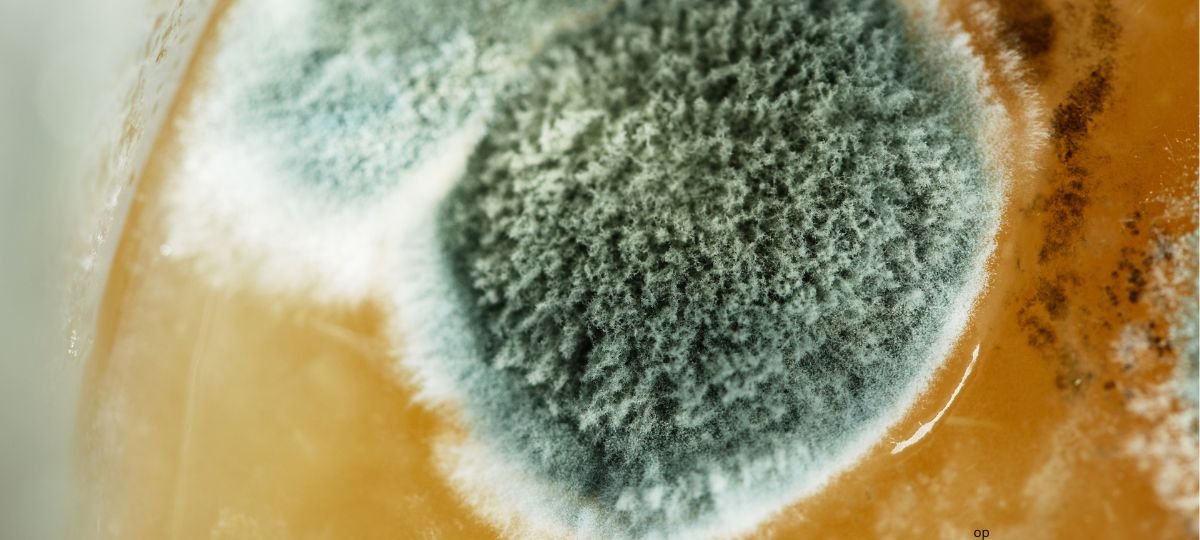

В TikTok появилось видео, как мужчина вскрывает упаковку популярного сока «Добрый» и обнаруживает там плесень. По его словам, продукт он приобрел в одном из магазинов сети «Евроопт».
@iiipak123 #сок#еврооптбеларусь #жестко #испорченныйсок ♬ оригинальный звук — Денис
«Я тут немного уже начал вскрывать.<….>Что это за жесть такая? Вот такое мы пьем», — прокомментировал автор ролика.
В самом начале видео мужчина уточнил, что на упаковке указан срок годности до июня 2025 года.
Видео, вызвало широкий резонанс среди пользователей в Сети. Одни начали шутить, что это «чайный гриб» или «настоявшиеся фрукты», другие писали, что плесень — это доказательство того, что «продукт натуральный».
Многие сошлись во мнении, что виноват именно производитель, а не магазин.
«Причем здесь магазины? Все вопросы к производителю! На лицо технологические нарушения или ошибки на производственном этапе, например, когда упаковка не была герметично закрыта, или когда сок не был должным образом обработан», — пишут в комментариях.
Другие предлагали обращаться непосредственно к производителям с просьбой проверить партию, составить акт в магазине и ждать реакции от компании.
«Звоните на предприятие, или возвращайте товар в магазин!» — отмечают комментаторы.
Были и те, кто сомневался в подлинности ситуации, считая видео постановочным и вспоминали историю с колбасой от Брестского мясомбината.
«Надо было снимать момент вскрытия упаковки», — пишет один из пользователей.
Между тем, автор в комментариях пояснил, что решил продолжить вскрывать коробку на камеру, потому что «вкус сока ему показался странным и в пробке было видно что плавает что-то».
Читайте также: «Это новый флешмоб?»: беларусы — об очередной «находке» в колбасе Брестского мясокомбината
Не первый случай
Инцидент с соком «Добрый» вызвал широкий отклик среди пользователей в Сети. Многие писали, что сами сталкивались с подобными ситуациями (оригинальные орфография и пунктуация сохранены).
«Я купила сок добрый яблоко. Сроки в норме, а сверху такая же плесень. Покупала ребннку. Хорошо, что сама попробовала. Брала в санте».
«У нас как то в ананасовом было такое. Сок Добрый наш любимый. Жаль очень что сейчас никакого контроля».
«Сама работаю в магазине и столкнулась с такой же проблемой, а именно с соком «Добрый». Сроки были не нарушены, но внутри пачки плесень. Пришлось списать всю партию».
«У нас такой же сок был только малиновый. В кружку падали какие-то сгустки как со.ли. после этого тоже разрезали коробку».
Как отреагирует на это видео производитель? Не исключено, что эта история послужит поводом для усиления контроля над качеством продуктов.
Читайте также: «Мы не знаем, когда вселимся в свой дом»: в Дрогичинском районе подрядчик оставил многодетную семью без жилья
Что делать, если нашли некачественный продукт?
В случае обнаружения проблем с продуктом (например, плесень в соке) следует предпринять следующие шаги:
- Проверить срок годности — если дата на упаковке корректна, а продукт не просрочен, скорее всего, проблема связана с неправильными условиями хранения или нарушением технологии производства.
- Обратиться в магазин — в случае обнаружения брака (в том числе плесени) нужно обязательно вернуть товар в магазин, где была сделана покупка. Составьте акт о возврате.
- Связаться с производителем — у большинства крупных производителей есть горячие линии для обработки рекламаций. Позвоните и расскажите о проблеме.
- Обращайте внимание на упаковку: если она вздута или повреждена, это может указывать на нарушение условий хранения. Лучше отказаться от покупки.
Будь на связи и в безопасности: подключи BGlobal VPN
Наш канал в Telegram. Присоединяйтесь!
Есть о чем рассказать? Пишите в наш Telegram-бот. Это анонимно и быстро

Сообщить об опечатке
Текст, который будет отправлен нашим редакторам: